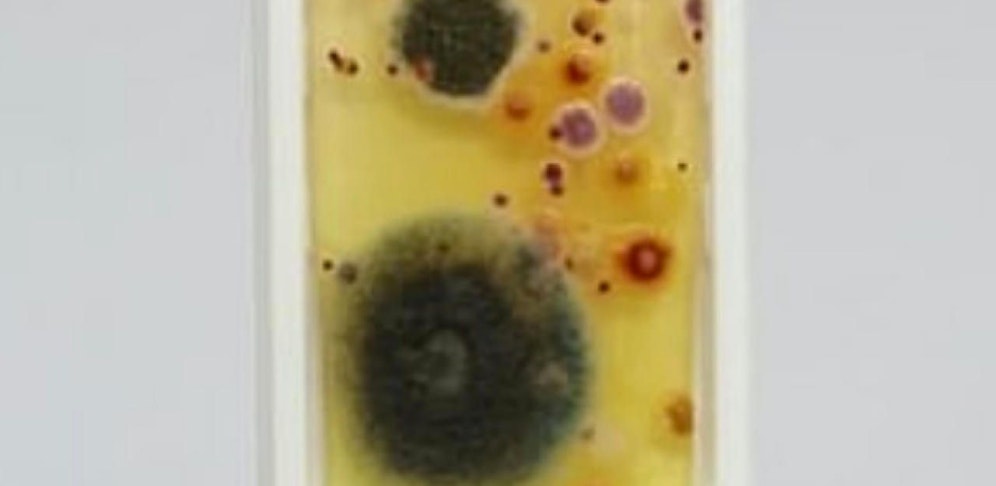

- Startseite
- Wetter
- Suchen
- Leser-Reporter
- Mein Profil
- Anmelden
- Neueste neue Artikel lesen
- Österreich
- Klima & Umwelt
- Olympia
- Song Contest
- Deutschland
- St. Pölten Wahl
- Nachrichten
- Sport
- Motor
- Life
- Unterhaltung
- Community
- Immobilien
- Jetzt im Kino
- TV-Programm
- Influencer-Award
- Kleine leisten Großes
- Sozial sicher in Wien präsentiert vom FSW
- Horoskop
- EssenHeute
- Tiere
- Videos
- Gewinnspiele
- E-Paper
- Newsletter
- Social Media